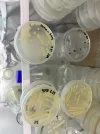
1.webp

Official annoncement:
just to talk about the basics of the previous pictures i have provided, no pictures is fake and all provided by the factory who produce my products, i have been honest and told you guys multiple time, it is an licensed manufacturer company where GenericAsia is being produced, yes it is true one member in herefound one of the customers/supplier sharing the SAME picture on their website, as i did here, that dont mean i lie or provide fake pictures.
secondly the picture i provided with GA and the date of 10.12.2024 - is now being accused of being fake, AI-generated and a lot more. These stupid accusations needs to stop, there is some few individuals out there trying to destroy my business and make these stupid claims about my pictures is AI-generated, which is IMPOSSIBLE TO BE DONE like that, look the god damn picture through, how can you guys says that is fake? -
thirdly yes the floors on the rooms is not matching, one is green and one is blue, and immediately you guys saying '' oh the floors color is not matching oh its fake '' seems like those individuals who keep making stupid claims and try to destroy my business here is clearly not aware of how an licensed manufacturer company works, there is multiple rooms where different equipments in, not my fault that you guys are used to order from an UGL lab with all machines in one basement, lol. it is an legimate manufacturer company with over 1000 employees and having over 20 different laboratories in that facility.
4. my products have not damaged anyone or killed anyone, all my products is being tested and provided. oh now yes, you dont have oxymetholone, well that will be on way as well and be online soon. just like the trenbolone e 200mg/ml you guys made an drama out of and actually was blind tested by an customer and provided as well, where is the comments for those goods stuff?
5. there is clearly a few individuals in here having something against GenericAsia or was given a few dollars to go stir up some drama in their forum, since i made USA domestic available it has been nothing but headache from those same guys in here.
6. i dont see the same effort or pressure on different sources in here who should be in the first place. my quality and service speaks for it self, seems like some one just cant accept nice competition.
7. here is the last laboratory pictures i share with you guys and will not be replying any more comments about my facility of pictures, a lot is showen. looking really forward to see who the next offer will be as i DONT SEE ANYTHING AT ALL on other sources, who should be held for accountable for less.
i would wonder whats the next drama subjects will be after these pictures.
- oh before i forget to mention, please have in mind these photos are from same facility just different laboratories, as you should understand by now it is an licensed manufacturer company.. i can understand some of you are used to only have ordered from UGL labs that have 10 equipments in one small warehouse